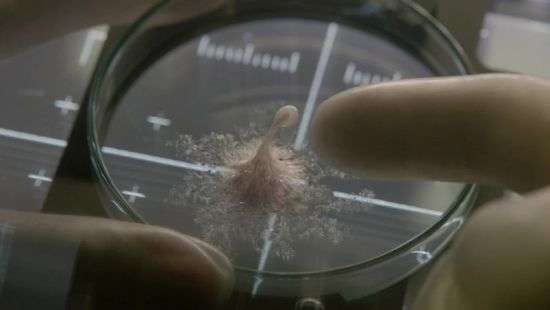
Фильм недели. Убийца с Марса

Рубрики
МЕНЮ
Фильм недели. Убийца с Марса
«Комментарии» знакомят читателей с самыми интересными премьерами в украинском кинопрокате

Виталий Войчук
"Живое" (англ. Life) — американский фантастический фильм ужасов, от режиссёра Даниэля Эспиносы.
Группа исследователей, находящихся на МКС, готовятся к перехвату возвращающегося с Марса модуля с образцами пород. При исследовании образцов подтверждается, что марсоход не ошибся при первичном анализе пород, и в них действительно есть жизнь: исследователи обнаруживают предположительно одноклеточное существо, которому на Земле присваивают имя Калвин (в честь 30-го Президента США).

Калвин представляет собой многоклеточный колониальный организм. После небольшого инцидента с разгерметизацией исследовательской камеры, Калвин впадает в оцепенение. При попытке вывести его из этого состояния электрическим шокером, он сначала ломает пальцы и кисть руки Хью Дерри (Эрион Бакаре), после чего демонстрируя небывалую сообразительность выбирается из камеры и убивает Роя, когда тот пытался спасти Хью.
Капитан экспедиции Катерина Головкина (Ольга Дыховичная) отдаёт приказ об уничтожении Калвина путём активации в лаборатории системы пожаротушения, чтобы он задохнулся, однако Калвин проникает в трубопровод. Калвин выбирается из трубопровода в космос и обхватывает скафандр Катерины, выведя из строя систему жизнеобеспечения, и Катерина погибает, захлебнувшись хладагентом скафандра.
Калвин через один из двигателей малой тяги проникает обратно на станцию. Исследователи принимают решение изолировать отсеки МКС друг от друга, однако Калвин уже проник под одежду Хью Дерри, и тот погибает. Дэвид и Миранда запираются в отсеке управления, а Шо скрывается в капсуле для сна. Калвин пытается сломать стекло капсулы, но потом возвращается к поглощению трупа Хью.

К МКС приближается космический корабль, который пристыковывается и пытается с помощью своих двигателей вывести МКС в свободный космос подальше от Земли, так как на Земле, получив сигнал бедствия, приняли решение уничтожить станцию целиком. Калвин убивает и Шо и прилетевший на Союзе экипаж, попутно сильно повредив станцию.
Дэвид летит в одну из капсул и запирается в ней с Калвином. В другой капсуле запирается Миранда. Капсулы отстыковываются и одна с Мирандой начинает торможение для входа в атмосферу Земли, а другая с борющимися внутри Дэвидом и Калвином пытается улететь всё дальше в космос.

Спускавшаяся капсула приводняется где-то в Азии. Капсула с Мирандой из-за столкновения с обломками МКС и вышедшей из строя системой наведения улетает всё дальше в космос.
Источником вдохновения для авторов этой картины послужил фильм "Чужой" (1979).
Фото: кадры из фильма "Живое".
Видео: Русские Трейлеры
Читайте Comments.ua в Google News
Новости партнеров


